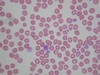

[Heme/Basic]
Hb nadir at __ months around 9-11 g/dL
Reticulocyte counts normalized <2% ≥ __ months
MCV nadir at __ months around 77fL
Hb nadir at 2-3 months around 9-11 g/dL
Reticulocyte counts normalized <2% ≥ 4 months
MCV nadir at 6-12 months around 77fL
[Heme/Anemia]
Cause of microcytic anemia? (4)
- Iron deficiency anemia
- Anemia of chronic disease (can be normocytic)
- Thalassemias
- Sideroblastic anemia

[Heme/Anemia]
Cause of normocytic anemia? (3)
- Hemolytic anemia
- Aplastic anemia
- Chronic renal disease

[Heme/Anemia]
Cause of macrocytic anemia? (4)
- Folate deficiency
- B12 deficiency
- Certain drugs: valproic acid
- Inherited bone marrow failure syndromes

[Heme/Anemia/β-thal]
β-thalassemia subtype?
Mild anemia, HbA2 > 3,5%: ___
Increased HbA2, HbF: __
Profound anemia by 6-12 months, pallor, frontal bossing, HSM, transfusion dependent: __
Mild anemia, HbA2 > 3,5%: minor
Increased HbA2, HbF: intermedia
HbF only, Profound anemia by 6-12 months, pallor, frontal bossing, HSM, transfusion dependent: major
[Heme/Anemia/ α-thal]
α-thalassemia subtype?
1) 1 locus, asymptomatic, no hematologic abnormalities (normal HbEP) (silent carrier): __
2) 2 loci, asymptomatic, MCV low, mild anemia (normal HbEP): __
3) 3 loci, moderate-to- severe hemolysis (HbH): __
4) 4 loci, death in utero (HbH, HbBart): __
1) 1 locus, asymptomatic, no hematologic abnormalities (silent carrier): trait
2) 2 loci, asymptomatic, MCV low, mild anemia: minor
3) 3 loci, moderate-to- severe hemolysis: HbH
4) 4 loci, death in utero: Hydrops fetalis
[Heme/Anemia]
Signs of which anemia?
Koilonychia

Iron deficiency anemia
(Sign of chronic iron deficiency)
[Heme/Anemia]
Which anemia?
Mentzer index (MCV/RBC) ≥ 13: __
Mentzer index (MCV/RBC) < 13: __
Mentzer index (MCV/RBC) ≥ 13: IDA
Mentzer index (MCV/RBC) < 13: thalassemia
[Heme/Anemia]
Which anemia?
Iron: low
TIBC: high
Transferrin saturation: low
Ferritin: low
Hepcidin: low
Iron deficiency anemia
[Heme/Anemia]
Which anemia?
Iron: low
TIBC: low
Transferrin saturation: low to normal
Ferritin: normal to high
Hepcidin: high
Anemia of chronic disease
[Heme/Anemia/Sickle]
Most common complications for sickle cell trait?
Hyposthenuria (inability to concentrate urine)
Renal papillary necrosis
[Heme/Hemoglobinopathies]
Diagnosis?

G6PD deficiency
(Heinz body and bite cells)
[Heme/HA]
What type of hemolytic anemia?
Treatment?
Acute pallor, jaundice, dark urine
After new medication, recent illness
PE: splenomegaly
Lab: direct Coombs positive,
(Warm) Autoimmune hemolytic anemia
- Treatment:
Corticosteroids
[Heme/HA]
What type of hemolytic anemia?
Older children, adolescent
Hemolytic anemia symptoms (dark urine, pallor)
After mycoplasma or EBV infection
Lab: direct Coombs test positive C3, negative IgG
Cold agglutinin disease
[Heme/HA]
What type of hemolytic anemia?
Children 4-10 years old
Acute abdominal, leg or back pain
Hemolytic anemia symptoms (dark urine, pallor)
After viral illness
Lab: direct Coombs test positive C3, negative IgG
Positive for cold-reacting IgG (Donath-Landsteiner antibodies)
Paroxysmal cold hemoglobinuria
[Heme/Stem cell disorders]
Which cell line affected?
Aplastic anemia: __
Aplastic crisis: __
Aplastic anemia: all cell line (pancytopenia)
Aplastic crisis: only red cells (true anemia)
[Heme/Red Cell Aplasia]
Diagnosis?
Management?
Children between 1 and 3 years old
Pallor, decreased activity
PE: no organomegaly, no petechiae
Lab: normocytic anemia, reticulocytopenia, (no other cytopenia)
Transient Erythroblastopenia of Childhood (TEC)
- Management:
Transfusion for symptomatic
Supportive care
(spontaneous resolution in 1-2 months)
[Heme/Transfusion]
Choice of transfusion and what prevented?
Selective IgA deficiency: __
Severe Combined ImmunoDeficiency: __
Aplastic anemia: __
Selective IgA deficiency: Washed, allergic reaction
Severe Combined ImmunoDeficiency: Irradiated, GVHD
Aplastic anemia: Leukoreduced (febrile non-hemolytic reaction) & Irradiated
[Heme/Neutropenia/Cong]
Which immune disorder
Its mechanism?
Age: in a few months of life
Sx:Recurrent severe bacterial infections, especially deep seated liver abscesses or osteomyelitis
Lab: Profound neutropenia
Severe congenital neutropenia (Kostmann syndrome)
Mechanism:
ELANE gene (m/c) or other gene defect
[Heme/Neutropenia/Cong]
Which syndrome?
Short stature, skeletal abnormalities
Imm: High fetal hemoglobin, neutropenia, myeloproliferateive malignancies
GI: Pancreatic dysfunction
Shwachman Diamond Syndrome
(Acinar cell hypoplasia)
[Heme/Neutropenia/Cong]
Diagnosis?
Mechanism?
Common organism for sepsis?
Neutropenia (ANC<200), interval of every 21 +/- 3 days
Fever, aphthous stomatitis, pharyngitis, cervical lymphadenitis, rectal/vaginal ulcers
Cyclic Neutropenia
- Mechanism:
ELA2 gene (defective maturation of uncommitted stem cells) - Common organism for sepsis:
Clostridium septicum
[Heme/Neutropenia/Acq]
Diagnosis?
Neutropenia in otherwise healthy newborn
Spontaneous resolution by 6-12 weeks
Mother with antineutrophil antibodies
Neonatal Isoimmune Neutropenia
[Heme/Neutropenia/Acq]
Diagnosis?
Persistently low ANC (0-500)
In otherwise healthy children (1-2 years)
Chronic Benign Neutropenia
(Autoimmune neutropenia)
[Heme/hemostasis]
Factors/medicaiton/lab for coagulation pathway?
Extrinsic: __
Intrinsic: __
Extrinsic: tissue factor, 7, warfarin, PT
(Waffle 먹고 밖에서 PT)
Intrinsic: 8, 9, 11, 12, heparin, PTT